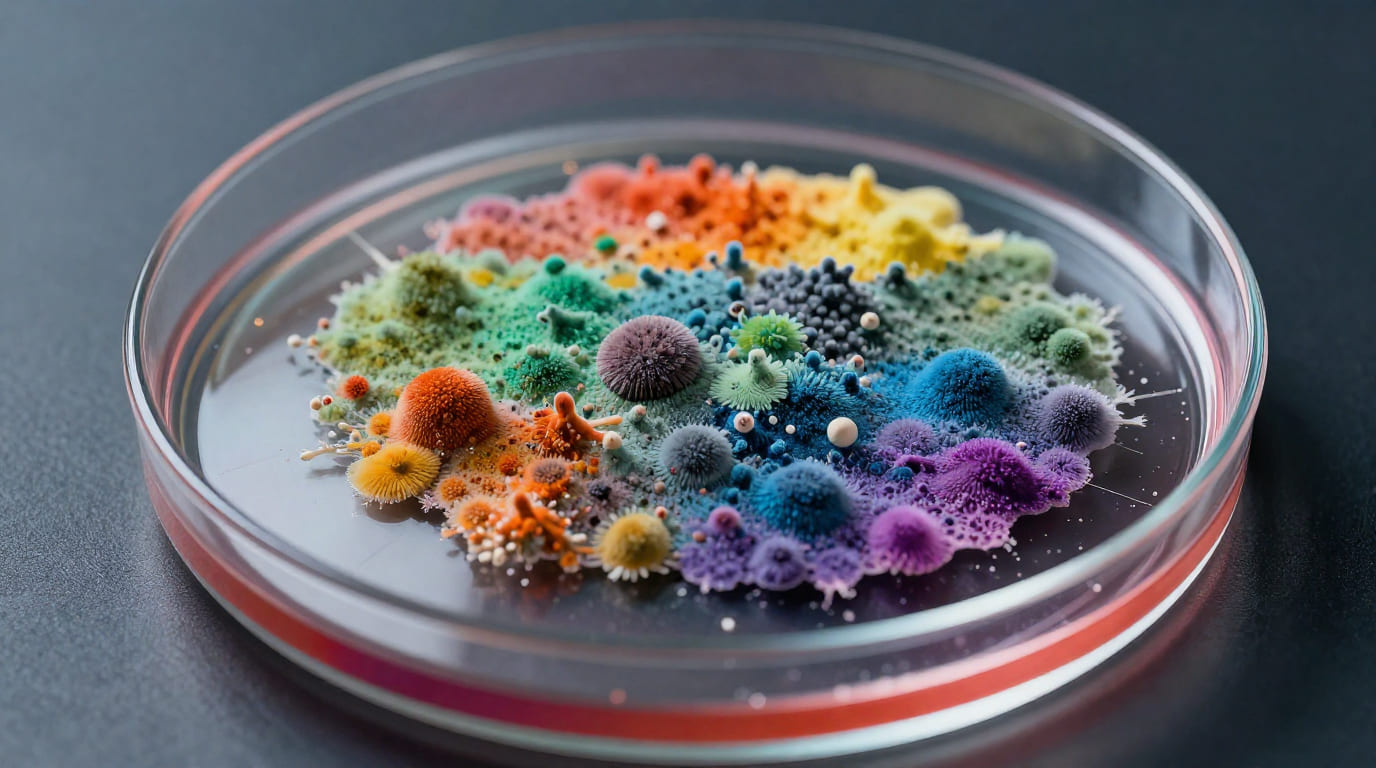
夢占い カビ

カビは、湿気が多く風通しの悪い場所に現れる、生活の中でできれば避けたい存在ですよね。掃除しても掃除しても出てくるカビに、うんざりした経験がある方も多いのではないでしょうか。
そんなカビが夢の中に登場したとき、一体どんなメッセージが隠されているのでしょうか。今回は、カビの夢の基本的な意味と、場所・物・行動など37のパターン別の意味について詳しく見ていきたいと思います。
カビの夢の基本的な意味とは?
意味その1「停滞・腐敗・衰退のサイン」
夢占いにおいて、カビはもっとも多く「停滞」や「腐敗」の象徴として登場します。カビが生えるのは、風通しが悪く、エネルギーの流れが止まった場所。夢の中でカビが現れるのは、あなたの生活や人間関係、気持ちの中に「停滞」や「腐りかけているもの」があるサインかもしれません。
長い間解決されていない問題、見て見ぬ振りをしてきた課題、あるいは惰性で続けている習慣——そういったものが夢の中でカビとして現れることがあります。カビが大きく広がっているほど、その問題が深刻化しているか、気力・体力が低下しているタイミングかもしれません。まずは「停滞していることがあるかもしれない」と認識することが、解決への第一歩です。
意味その2「健康・生活環境への警告」
カビの夢でよく語られるもう一つの意味が、健康面や生活環境への警告です。カビは実際に人体にも悪影響を及ぼす存在。夢の中でもそのイメージが反映され、「体が弱っていませんか」「生活環境を見直してください」というメッセージとして現れることがあります。
特に、体にカビが生える夢や、食べ物にカビが生える夢は、健康運の低下や体のサインへの注意を促すケースが多いと言われています。最近、疲れが取れない・免疫が落ちている・食生活が乱れているといった自覚がある方は、この夢をきっかけに生活習慣を見直してみることをおすすめします。
意味その3「変化・浄化・再生の前触れ」
カビはネガティブなイメージが強い一方で、「分解者」として自然界の循環を担っている側面もあります。夢占いにおいても、カビを掃除したり除去したりする夢は、浄化や再生、問題解決の兆しとして解釈されることがあります。
カビを落とし、きれいに取り除いた後の清々しさは、「古いものを手放して新しくスタートできる」ことの象徴です。カビだらけだった場所が綺麗になる夢は、ネガティブな出来事が好転に向かう吉夢として受け取るとよいでしょう。悪化の前兆ではなく、変化のきっかけとして捉えてみてください。
カビの夢は吉夢?凶夢?(判定のポイント)
カビの夢の吉凶は、主に「カビの状態」と「夢の中の行動」で判断します。
カビが増え広がっていく夢・カビだらけで手がつけられない夢は、問題の深刻化や健康・運気の低下を示す凶夢寄りのメッセージとなりやすいです。一方、カビを掃除・除去・捨てる夢は、問題解決や運気好転を示す吉夢として解釈されます。
また、夢の中での感情も重要です。カビを見て強い不快感を覚えた場合は警告のサイン、不思議と気にならなかった場合は現状を客観的に見つめ直すタイミングを示していることがあります。
心理学から見たカビの夢
フロイトの精神分析では、カビのような「腐敗・分解するもの」は、抑圧されてきた感情や欲求が変質し、行き場を失っている状態を象徴するとされています。長い間溜め込んだ不満・怒り・悲しみが、夢の中でカビとして現れることがあるのです。
また、行動心理学の観点からは、カビの夢は「コントロールできない恐怖」の象徴として解釈されることもあります。見えないところから静かに広がっていくカビのイメージは、自分の知らないうちに状況が悪化しているのではという潜在的な不安を映し出しているのかもしれません。
いずれにせよ、カビの夢は深層心理が「今こそ向き合う時だよ」と教えてくれているサインです。問題を直視し、早めに対処していくことで、カビを根こそぎ落とすように状況を好転させることができるでしょう。
【場所別】カビの夢の意味(家・部屋の中のカビ)
1. 部屋(室内)にカビが生える夢
自分の部屋にカビが生えている夢は、あなたのプライベートな空間や内面に停滞が生じていることの暗示です。「安らげる場所がなくなってきた」「心のよりどころが脅かされている」という潜在的な不安を反映していることがあります。
部屋は「自分自身の心の空間」を象徴します。カビが生えた場所や範囲によって、どのジャンルで停滞が起きているかが変わりますが、まずは自分の心の状態を整えることが先決です。気持ちをリセットできるルーティンを作ることで、「心のカビ」を払拭していきましょう。
2. 壁や天井にカビが生える夢
壁や天井にカビが生える夢は、生活基盤や精神的な支柱が揺らいでいることを示すことがあります。壁は「守り」や「境界線」の象徴、天井は「限界」や「目標の上限」を意味します。
特に天井のカビは、自分の目標や可能性に制限がかかっているサインと解釈されることがあります。「これ以上は無理かもしれない」という思い込みや、外からの圧力がプレッシャーになっていないか振り返ってみてください。
3. キッチン(台所)にカビが生える夢
キッチンは生命を維持するための食を生み出す場所。そこにカビが生える夢は、生活力や生命エネルギーの低下、あるいは食生活や健康面の乱れへの警告として解釈されます。
栄養バランスの偏り・不規則な食事・睡眠不足など、日常生活の基本的な部分が崩れていないか確認してみてください。基本的な生活習慣を整えることで、運気も体も回復に向かっていくでしょう。
4. お風呂・浴室にカビが生える夢
浴室はもともとカビが生えやすい場所ですが、夢の中で印象的に登場する場合は意味が異なります。浴室は「浄化」「リセット」の象徴。そこにカビが生える夢は、心身の浄化や気分転換ができていないことの反映かもしれません。
ストレスや疲れが溜まっているにもかかわらず、解消できる機会が少なくなっているサインかもしれません。意識的にリラックスする時間をつくり、心と体をリセットすることを心がけてみてください。
5. トイレにカビが生える夢
トイレは「不要なものを排出する場所」という象徴的な意味を持ちます。そこにカビが生える夢は、排出・解放できていない感情や問題が溜まっていることを示していることがあります。
「言いたいことが言えない」「感情を溜め込んでいる」という状態が続いているなら、この夢がそのことを教えてくれているのかもしれません。信頼できる人に気持ちを打ち明けたり、日記やメモに書き出したりすることで、心の中の「詰まり」を解消していきましょう。
6. クローゼット・押し入れにカビが生える夢
クローゼットや押し入れは「隠しているもの」「しまい込んでいるもの」の象徴です。そこにカビが生える夢は、長い間しまい込んでいた問題や感情が限界に達しつつあることを示しているかもしれません。
「見て見ぬ振りをしてきたことが、そろそろ限界」というメッセージです。思い切って扉を開け、中を整理するように、抱えてきた課題と向き合うタイミングが来ているのかもしれません。
7. カビだらけの古い家の夢
家全体がカビだらけの古い夢は、古いしがらみや過去の傷、昔のネガティブな記憶が今の自分に影響を与えていることの象徴かもしれません。「過去にとらわれている」「昔の失敗を引きずっている」という状態を夢が映し出していることがあります。
古い家は変えることができませんが、その中のカビを掃除することはできます。過去を変えることはできなくても、その意味の捉え方を変え、今を新しく生きていくことができます。過去の清算に向き合うことが、次のステップへの近道でしょう。
8. 押し入れや窓のないカビが広がる夢
窓や出口がなく閉じた空間でカビが広がっていく夢は、閉塞感や逃げ場のない状況への強い不安を反映していることがあります。選択肢がない、出口が見えないという感覚が、夢の中で広がるカビとして表現されているのかもしれません。
まずは「出口はある」と信じることが大切です。閉塞感を感じているなら、視野を少し広げることで新しい選択肢が見えてくることがあります。
【物・モノ別】カビの夢の意味
9. 食べ物(全般)にカビが生える夢
食べ物にカビが生える夢は、健康運の低下を示す代表的なパターンです。食べ物は「生命力の源」を象徴しており、そこにカビが生えることは、体のエネルギーが枯渇しつつあるサインかもしれません。
食生活の乱れ・睡眠不足・過労など、健康に影響を与えている要因がないか振り返ってみてください。早めに休息を取り、体の声に耳を傾けることが大切です。
10. パン・ご飯(主食)にカビが生える夢
パンやご飯など、日常的に食べる主食にカビが生える夢は、日常生活の基盤が揺らいでいることを示すことがあります。「当たり前に続いていたことが壊れる」「生活の基本的な部分に問題が生じる」という暗示として解釈されます。
ご飯にカビが生える夢は特に、家族や身近な人との関係に変化が訪れるサインとも言われています。普段当たり前に感じている日常生活への感謝と注意を、あらためて持ってみてください。
11. 果物にカビが生える夢
果物は恋愛や感情面の豊かさを象徴することが多いアイテムです。果物にカビが生える夢は、恋愛運の低下や、感情的な充実感が損なわれていることの暗示として解釈されることがあります。
恋人との関係がマンネリ化していたり、感情的に疲れていたりするタイミングに見やすい夢です。大切な人との時間を意識的につくったり、自分の感情と向き合う機会を持つことで、関係の「カビ」を取り除いていきましょう。
12. 服・衣類にカビが生える夢
服は自己表現や社会的なイメージの象徴です。服にカビが生える夢は、自己イメージの低下や、外見への不安が高まっていることを示す場合があります。「人にどう見られているか気になる」「自分の印象が悪くなっているのではないか」という潜在的な心配が夢に現れているかもしれません。
また、社会的な評価や立場の低下への警戒サインとも解釈されます。自分らしい表現方法を取り戻すことで、自信と輝きが戻ってくるでしょう。
13. 布団・ベッドにカビが生える夢
布団やベッドは「休息」「安心感」「心の安らぎ」を象徴します。そこにカビが生える夢は、心身の疲労が回復できていないことや、安心できる環境が損なわれているサインかもしれません。
「眠れない」「休んでも休んだ気がしない」という状態が続いているなら、この夢がそのことを伝えてくれているのかもしれません。まずは、自分を休める環境づくりと、気持ちをリラックスさせる工夫から始めてみてください。
14. 財布・バッグにカビが生える夢
財布は「金運」や「豊かさ」、バッグは「行動力」や「内面のリソース」を象徴します。財布やバッグにカビが生える夢は、金運の低下や出費の増加、あるいは行動力やエネルギーの停滞を示すことがあります。
お金の管理を見直したり、無駄な出費を抑えたりするタイミングかもしれません。また、やりたいことがあるのに先延ばしにしているなら、その停滞がカビとして表れている場合もあります。
15. 本・書類にカビが生える夢
本や書類にカビが生える夢は、知識や情報、あるいは重要な計画や約束ごとが「腐っている」すなわち活用されていないまま眠っていることを示していることがあります。
「勉強しようと思っていたのにできていない」「重要な書類を後回しにしている」といった状況がある場合、この夢がそのことを教えてくれているのかもしれません。大切なことを先送りにせず、今できることから手をつけてみましょう。
【体・身体別】カビの夢の意味
16. 体(全般)にカビが生える夢
体全体にカビが生える夢は、健康運の大幅な低下を警告していることがあります。特に免疫力の低下、慢性的な疲労、精神的なダメージが蓄積されている状態の反映として解釈されることが多いです。
心身の疲弊が限界に達している可能性があります。まずは十分な休息を取り、体の声に耳を傾けてください。深刻な症状があれば、医療機関への相談も視野に入れてみてください。
17. 顔にカビが生える夢
顔にカビが生える夢は、対人関係や社会的な評価に関する不安を示していることがあります。顔は人に見せる部分であり、自己表現と社会的なアイデンティティの象徴です。
「周囲にどう見られているか」「評価が下がっているのではないか」という焦りや不安が夢に表れている可能性があります。自分自身の本来の魅力を信じ、他者の評価に振り回されすぎないことが大切です。
18. 頭・髪にカビが生える夢
頭や髪にカビが生える夢は、思考力や判断力の低下を示すことがあります。頭は「考える」「判断する」機能の象徴であり、そこにカビが生えることは、「思考が停滞している」「判断力が鈍っている」サインかもしれません。
重要な決断を迫られているタイミングには、一度立ち止まって頭を休めることが大切です。十分な睡眠と休養を取ることで、思考がクリアになっていくでしょう。
19. 腕にカビが生える夢
腕は「行動力」「実行する力」「チャンスをつかむ力」の象徴です。腕にカビが生える夢は、本来の行動力や実行力が発揮できていない状態を示していることがあります。
チャンスが目の前にあっても踏み出せない、やりたいことがあるのに動けないという状態が続いているなら、この夢がそのことを映し出しているのかもしれません。小さな行動から始めて、体を動かすことで流れを変えていきましょう。
20. 足にカビが生える夢
足は「前進する力」「生活基盤の安定」を象徴します。足にカビが生える夢は、経済状態の悪化や仕事上の不調、あるいは人生の方向性が迷子になっていることの暗示として解釈されることがあります。
「このまま進んでいいのだろうか」という迷いや、生活面での不安が夢に表れているのかもしれません。足元をしっかりと固め、一歩一歩着実に進んでいくことが、状況を好転させる鍵となるでしょう。
21. 手にカビが生える夢
手は「人とのつながり」「働くこと」「与える・受け取る」という行為を象徴します。手にカビが生える夢は、対人関係での停滞や、コミュニケーションにおける問題を示していることがあります。
「誰かに連絡しようと思っていたのに先延ばしにしている」「職場での人間関係がうまくいっていない」という状況があるなら、この夢がそれを反映しているかもしれません。積極的に手を差し伸べることで、関係が改善に向かうでしょう。
22. 他人(知人・家族)にカビが生える夢
身近な人にカビが生える夢は、その人に対する心配や不安を反映していることがあります。「あの人は最近元気かな」「何か問題を抱えているのではないか」という潜在的な気がかりが夢に現れることがあります。
気になる相手がいるなら、連絡を取ってみることが大切です。また、その人があなたとの関係において何か変化が生じていることを示す場合もあります。思いやりを持って接することで、良い関係が保たれていくでしょう。
【行動・状況別】カビの夢の意味
23. カビを見つける夢
カビが生えていることに気づく・発見する夢は、今まで見えていなかった問題が表面化することの前触れかもしれません。「気づき」そのものを象徴する夢であり、発見した後にどう対処したかがポイントになります。
カビを見つけてすぐに行動しようとした夢なら、問題解決への意欲があるサインです。一方、見てもそのまま放置した夢なら、見て見ぬ振りをしていることへの警告と受け取ってください。問題は発見した瞬間が対処の最善タイミングです。
24. カビを掃除する・拭き取る夢
カビを一生懸命に掃除したり、拭き取ったりする夢は、運気の上昇や問題解決に向けて積極的に動いていることの吉夢です。苦労や問題に正面から向き合い、克服しようとしているあなたの意志力の反映と言えます。
掃除がうまくいって綺麗になった夢なら、問題解決や悩みの解消に向かう吉兆として受け取ってください。努力が報われる時期が近づいているかもしれません。積極的に動いていきましょう。
25. カビを落とす・除去する夢
カビ取りスプレーや洗剤でカビを根こそぎ落とす夢は、問題の根本的な解決を望む深層心理の反映です。表面的な対処ではなく、根本から改善しようとする意志の強さを示しています。
特に、カビが綺麗に落ちてスッキリした感覚があった夢なら、長年の悩みや課題がいよいよ解決に向かう吉夢です。積み上げてきた努力が実を結ぶ、嬉しい展開が待っているかもしれませんね。
26. カビを捨てる夢
カビが生えたものを思い切って捨てる夢は、不要なものを手放す決断を象徴する吉夢です。執着していたもの・関係・考え方を手放し、新しい自分へと生まれ変わろうとしているサインかもしれません。
「断捨離」のように、古いものを手放すことで新しいエネルギーが入ってくることがあります。捨てることへの罪悪感よりも、手放した後の清々しさを想像して、前向きに進んでみてください。
27. カビが生えた食べ物を気づかずに食べる夢
気づかないうちにカビが生えた食べ物を食べてしまう夢は、知らないうちに悪影響を受けているかもしれないという警告として解釈されます。周囲の環境や人間関係の中に、あなたの気づかないところで悪意や毒が潜んでいる可能性への注意を促していることがあります。
ただし、食べても何も感じなかった夢なら、問題があっても乗り越えられる強さがある暗示でもあります。情報収集と注意を意識しながら、慎重に行動してみてください。
28. カビが生えた食べ物とわかって食べる夢
カビが生えているとわかっていながら食べる夢は、悪いとわかっていながらも問題のある状況を続けている自分への警告かもしれません。「ここにいるとよくないとわかっている」「この習慣はよくないとわかっている」けれどやめられないという状態の反映である可能性があります。
現状に対してある程度の自覚があるなら、それが改善への第一歩になります。一度立ち止まって、変えるべき状況と向き合うことが大切なタイミングかもしれません。
29. カビが増える・広がっていく夢
みるみるうちにカビが広がっていく夢は、問題や悩みが拡大しつつあることの警告です。「このまま放っておくと手がつけられなくなる」という深層心理からのアラームとして受け取ってください。
早期対処が最善策です。問題が大きくなるほど解決が難しくなりますが、今の段階ならまだ間に合います。まず一番気になる課題に絞り、小さな行動から始めてみることをおすすめします。
30. カビが消える夢
あったはずのカビがいつの間にか消えている夢は、悩みや問題が自然と解消に向かうことの吉夢です。誰かのサポートや、時間の経過が問題を解決してくれる予兆として受け取ってください。
また、「気にしていたことが気にならなくなる」という心理的な変化のサインでもあります。焦らずにいれば、自然と良い方向に向かっていくでしょう。今は流れを信じて待つことも大切なことがあります。
【特徴・色別】カビの夢の意味
31. 緑色のカビの夢
緑色のカビは現実にも多く見られる種類ですが、夢の中では「自然な停滞・成長の歪み」を象徴することがあります。緑は本来、成長や生命力を示す色ですが、カビと組み合わさることで「本来の成長が阻害されている」という意味合いが生まれます。
能力や可能性があるにもかかわらず、それが発揮できていない状況のサインかもしれません。あなたの本来の力を取り戻すために、環境を変えることや、新しい学びを始めることを考えてみてください。
32. 黒いカビの夢
黒いカビの夢は、健康への警告や深刻な問題のサインとして受け取ることができます。黒は「危険」「強さ」「深刻さ」を象徴する色であり、黒いカビが印象的な夢は、看過できない問題が潜んでいる可能性を示していることがあります。
特に体や食べ物に黒いカビが生えていた場合は、健康面や生活面での早急な対処が必要なタイミングかもしれません。専門家への相談や、信頼できる人への打ち明けも視野に入れてください。
33. 白いカビの夢
白いカビは「変化の過渡期」を示すことがあります。白は浄化や新しさのシンボルでもあるため、白いカビの夢はネガティブなもの(停滞・腐敗)が少しずつ変容しつつある過程の反映かもしれません。
「よくないものが変わり始めている」というメッセージとして前向きに捉えることもできます。問題が解決に向かいつつある途中段階かもしれませんので、諦めずに継続して取り組んでいきましょう。
34. 臭い(においが強烈な)カビの夢
カビの臭いが強烈な夢は、目に見えないところで問題が進行していることへの警告として解釈されることがあります。臭いは「見えないものに気づくための感覚」であり、夢の中で強い臭いを感じたということは、表面には現れていない問題への敏感さを示しています。
直感的に「何かおかしい」と感じていることがあれば、その感覚を大切にしてください。早めに調べたり確認したりすることで、問題が大きくなる前に手を打てるかもしれません。
35. 大量のカビの夢
どこを見てもカビだらけという夢は、多くの問題が一度に重なっているか、ストレスや疲労が限界に達していることを示している可能性があります。問題の「量」や「範囲」が夢の中で大量のカビとして表現されているのかもしれません。
全部を一度に解決しようとせず、優先順位をつけて一つずつ対処することが大切です。どれだけ大量のカビでも、一つ一つ丁寧に取り除いていけばいつか綺麗になります。焦らず、着実に進んでいきましょう。
36. カビがきれいに掃除されている夢
すでに綺麗に掃除されてカビが完全に除去されている状態を夢で見た場合、問題やトラブルがすでに解決しているか、もしくはこれから解決に向かうことの吉兆です。誰かの助けを借りて状況が好転するという予兆のこともあります。
清潔で気持ちの良い感覚を覚えた夢なら、運気の上昇と新しいスタートを予感させる吉夢として受け取ってください。
37. カビが人に移る夢(感染する夢)
カビが自分から他人に移る、または他人から自分にカビが移ってくる夢は、ネガティブなエネルギーや問題が人から人へと伝播することの象徴かもしれません。周囲の人のネガティブな状況や感情に影響を受けやすくなっているサインとも解釈されます。
エネルギーを吸い取られるような人間関係や環境には注意が必要かもしれません。適切な「距離感」を保つことで、自分自身を守ることができます。人の問題を全部自分で抱え込まないように心がけてみてください。
よくある質問(FAQ)
Q. カビの夢は吉夢ですか?凶夢ですか?
A. カビの夢は基本的には健康運の低下や問題の停滞を示す警告夢として解釈されることが多いですが、カビを掃除・除去・捨てる夢は運気上昇の吉夢とされます。夢の中の行動と感情が判断の鍵です。カビが広がる・増えるなら注意が必要、カビを取り除けたなら問題解決の兆しと受け取るとよいでしょう。
Q. カビを掃除する夢は良い夢ですか?
A. はい、カビを掃除する夢は運気上昇の吉夢として解釈されることが多いです。問題に正面から向き合い、自ら解決しようとする行動力と意志力を示しています。特に掃除がうまくいってスッキリした感覚があった夢なら、悩みの解消や状況の好転が期待できます。現実でも積極的に行動することで良い結果が生まれやすい時期です。
Q. カビの夢を繰り返し見るのはなぜですか?
A. 繰り返しカビの夢を見る場合、現実の生活の中で解消されていない問題・ストレス・健康上の不安などを深層心理が繰り返し訴えているサインかもしれません。「早く向き合って」というメッセージとして、同じテーマの夢が続いていると考えられます。放置している課題や、向き合えていない感情と少しずつ向き合うことで、夢の内容が変わっていくでしょう。
まとめ
今回は、カビの夢について場所別・物別・体別・行動別・色別と、さまざまなパターンから解説してきました。カビがどこに生えているか、どんな行動をしたかによって、意味は大きく変わります。
カビの夢は警告的な意味を持つことが多いですが、夢の中で積極的に掃除したり取り除いたりしていたなら、解決への意志の強さを示す前向きなメッセージでもあります。
カビの夢が伝えているメッセージを受け止め、停滞しているものを一つ一つ取り除いていくような気持ちで、日常生活を前向きに見直してみてくださいね。